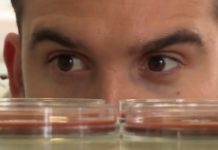
Is kissing disgusting?

About National Geographic Kids: Nat Geo Kids makes it fun to explore your world with weird, wild, and wacky videos! Videos featuring awesome animals, cool science, funny pets, and more, are made just for curious kids like you. So pick a topic you love and start watching today!